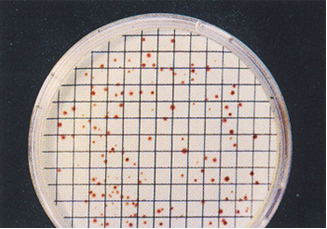

SB Enterococos SLANETZ-BARTLEY TTC BROTH es la versión líquida del SB Agar para emplear en placas con cartón absorbente
Medio preparado para recuento de Enterococos en aguas, por la técnica de Filtración de Membrana (MF)
Referencia: RPL046 (Vial pinchable 100 ml) , FPL501 (Vial 2 ml). Proteger de la luz! No existe medio deshidratado en versión caldo. Tambien disponible Slanetz-Bartley M-Enterococcus Agar en polvo, DMT115.
INTRODUCCIÓN
La nueva Directiva de las Comunidades Europeas para control de las aguas de consumo humano (3/XI/1998), establece que debe controlarse sistemáticamente la ausencia de Enterococos en todo tipo de agua de consumo humano (muestras de 100 ml en aguas de red y en aguas que intervienen en la fabricación de alimentos, y de 250 ml en aguas envasadas).
Este parámetro es indicador de contaminación fecal más lejana en el tiempo (o en la distancia desde el foco emisor) que el parámetro E.coli, incapaz éste de sobrevivir en el agua mucho más de 24 horas. Por ello resulta de gran importancia la adición de este parámetro en el análisis rutinario de todo tipo de aguas de consumo humano.
El medio KAA,
que MICROKIT siempre ha promocionado por dar resultados en sólo 24 horas, es excelente para detectar toda clase de Estreptococos fecales-grupo D de Lancefield (los Enterococos, de origen humano, y los estreptococos fecales strictu sensu, de origen bovino y equino) por lo que resulta más rigurosa la comprobación de su ausencia que la de Enterococos y, por tanto, a nadie debe extrañar que muchos laboratorios continúen utilizándolo.
Sin embargo, los laboratorios oficiales y otros muchos vendrán obligados a utilizar medios específicos de Enterococos. Por ello, Laboratorios MICROKIT ha diseñado el medio de Slanetz-Bartley, sumamente selectivo, en caldo preparado con TTC incluido, para Filtración de Membrana con cartón absorbente (o, quien lo prefiera, para añadirle 15 g/l de agar-agar DMT001, fundido y enfriado a 50°C en el momento de dispensación en placas), a fin de que todo laboratorio pueda utilizar este medio, ya preparado, sin necesidad de preparar y fundir a 98°C el clásico Slanetz-Bartley Agar. Se ha elegido este medio, también llamado M-Enterococcus, en vez del KF por haber demostrado en numerosas publicaciones que da lugar a muchos menos falsos positivos, incluso en agua de mar.
MODO DE EMPLEO E INTERPRETACIÓN DE RESULTADOS
1-Por cada muestra que vaya a analizar, tome con una jeringa estéril 2 ml de M-Enterococcus Slanetz-Bartley TTC Broth del vial pinchable RPL046 o del vial 2 ml FPL501.
2-Añada 2 ml a cada placa estéril con cartón absorbente VDA001.
3-Deposite encima la membrana filtrante VAC073 de 47 mm de diámetro y 0,45 µm de poro por la que habrá filtrado 100 (ó 250) ml de muestra de agua (aparato de filtración VFR012).
4- Preincubar 4 horas a 37°C aproximadamente y, acto seguido, incubar 44 horas a 44-45°C aproximadamente.
5- Si aparece alguna colonia diminuta, de color rojo, rosa o pardo-rojizo, se diagnostica como procedente de Enterococos, por lo que el agua es susceptible de contener patógenos de procedencia fecal. El color rojizo de las colonias es menos intenso cuanto más viejo es el medio.
6- Para una confirmación específica más precisa utilice las galerías enzimáticas (4 h) para estreptococos KBH254, y/o bien el kit PYR (KWD103), que diferencia Enterococos del resto de Estreptococos Fecales.
Control de calidad positivo: CRIOSTRAIN Enterococcus faecalis MKTA 29212
VER TAMBIEN MUG PLUS E.COLI CHROMOGENIC MEDIUM Y M-CP CLOSTRIDIUM PERFRINGENS MEDIUM.
El usuario final es el único responsable de la eliminación de los microorganismos según la legislación medioambiental vigente. Autoclavar antes de desechar a la basura.
Si desea más información sobre nuestros M-ENTEROCOCCUS SLANETZ-BARTLEY TTC BROTH rellene nuestro formulario de contacto http://www.medioscultivo.com/contacto . O si lo prefiere póngase en contacto con nosotros a través de nuestro correo electrónico microkit@microkit.es o por teléfono en el nº 91-897 46 16
https://www.microkit.es/monograficos/16-Enterococos-fecales-monograf–a.pdf